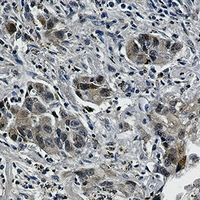

Product Name :
EGFR (Phospho-Y1173) Rabbit monoclonal antibody Background :
The epidermal growth factor (EGF) receptor is a 170 kDa transmembrane tyrosine kinase that belongs to the HER/ErbB protein family. Research studies have shown that somatic mutations in the tyrosine kinase domain of EGF receptor (EGFR) are present in a subset of lung adenocarinomas that respond to EGFR inhibitors, such as gefinitib and erlotinib. Two types of mutations account for approximately 90% of mutated cases: a specific point mutation, L858R, that occurs in exon 21 and short in-frame deletions in exon 19 . The most frequent exon 19 deletion is E746-A750, accounting for 90% of lesions at this site, although some rare variants occur. Product :
Liquid in 50mM Tris-Glycine (pH 7.4), 0.15M NaCl, 50% Glycerol, 0.01% Sodium azide and 0.05% BSA. Storage&Stability :
Store at 4°C short term. Aliquot and store at -20°C long term. Avoid freeze-thaw cycles. Specificity :
Recognizes endogenous levels of EGFR (pY1173) protein. Immunogen :
A synthetic phosphopeptide corresponding to residues surrounding Tyr1173 of human EGFR Conjugate :
Unconjugated Modification :
Phosphorylation
EGFR (Phospho-Y1173) Rabbit monoclonal antibody Background :
The epidermal growth factor (EGF) receptor is a 170 kDa transmembrane tyrosine kinase that belongs to the HER/ErbB protein family. Research studies have shown that somatic mutations in the tyrosine kinase domain of EGF receptor (EGFR) are present in a subset of lung adenocarinomas that respond to EGFR inhibitors, such as gefinitib and erlotinib. Two types of mutations account for approximately 90% of mutated cases: a specific point mutation, L858R, that occurs in exon 21 and short in-frame deletions in exon 19 . The most frequent exon 19 deletion is E746-A750, accounting for 90% of lesions at this site, although some rare variants occur. Product :
Liquid in 50mM Tris-Glycine (pH 7.4), 0.15M NaCl, 50% Glycerol, 0.01% Sodium azide and 0.05% BSA. Storage&Stability :
Store at 4°C short term. Aliquot and store at -20°C long term. Avoid freeze-thaw cycles. Specificity :
Recognizes endogenous levels of EGFR (pY1173) protein. Immunogen :
A synthetic phosphopeptide corresponding to residues surrounding Tyr1173 of human EGFR Conjugate :
Unconjugated Modification :
Phosphorylation
-
 Western blot analysis of EGFR (pY1173) expression in Hela (A), A549 (B) whole cell lysates.
Western blot analysis of EGFR (pY1173) expression in Hela (A), A549 (B) whole cell lysates. -
Immunohistochemical analysis of EGFR (pY1173) staining in human lung cancer formalin fixed paraffin embedded tissue section. The section was pre-treated using heat mediated antigen retrieval with sodium citrate buffer (pH 6.92). The section was then incubated with the antibody at room temperature and detected using an HRP conjugated compact polymer system. DAB was used as the chromogen. The section was then counterstained with haematoxylin and mounted with DPX.
Immunohistochemical analysis of EGFR (pY1173) staining in human lung cancer formalin fixed paraffin embedded tissue section. The section was pre-treated using heat mediated antigen retrieval with sodium citrate buffer (pH 6.92). The section was then incubated with the antibody at room temperature and detected using an HRP conjugated compact polymer system. DAB was used as the chromogen. The section was then counterstained with haematoxylin and mounted with DPX. -
 Immunohistochemical analysis of EGFR (pY1173) staining in human lung cancer formalin fixed paraffin embedded tissue section. The section was pre-treated using heat mediated antigen retrieval with sodium citrate buffer (pH 6.92). The section was then incubated with the antibody at room temperature and detected using an HRP conjugated compact polymer system. DAB was used as the chromogen. The section was then counterstained with haematoxylin and mounted with DPX.
Immunohistochemical analysis of EGFR (pY1173) staining in human lung cancer formalin fixed paraffin embedded tissue section. The section was pre-treated using heat mediated antigen retrieval with sodium citrate buffer (pH 6.92). The section was then incubated with the antibody at room temperature and detected using an HRP conjugated compact polymer system. DAB was used as the chromogen. The section was then counterstained with haematoxylin and mounted with DPX.
Bioworld Biotech only provide peptides for our antibodies and do not provide additional peptide customization services.
Price/Size :
USD 368/1mg/vial
Tips:
For phospho antibody, we provide phospho peptide(0.5mg) and non-phospho peptide(0.5mg).Describe :
Blocking peptides are peptides that bind specifically to the target antibody and block antibody binding. These peptide usually contains the epitope recognized by the antibody. Antibodies bound to the blocking peptide no longer bind to the epitope on the target protein. This mechanism is useful when non-specific binding is an issue, for example, in Western blotting (WB) and Immunohistochemistry (IHC). By comparing the staining from the blocked antibody versus the antibody alone, one can see which staining is specific; Specific binding will be absent from the western blot or IHC performed with the neutralized antibody.Formula:
Synthetic peptide was lyophilized with 100% acetonitrile and is supplied as a powder. Reconstitute with 0.1 ml DI water for a final concentration of 10 mg/ml.The purity is >90%,tested by HPLC and MS.
Storage:
The freeze-dried powder is more stable. For short time at 2-8°C. For long term storage store at -20°C.
Note :
This product is for research use only (RUO only). Not for use in diagnostic or therapeutic procedures.
 EGFR (Phospho-Y1173) Rabbit monoclonal antibody
EGFR (Phospho-Y1173) Rabbit monoclonal antibody  Datasheet
Datasheet COA
COA MSDS
MSDS SHIP
SHIP